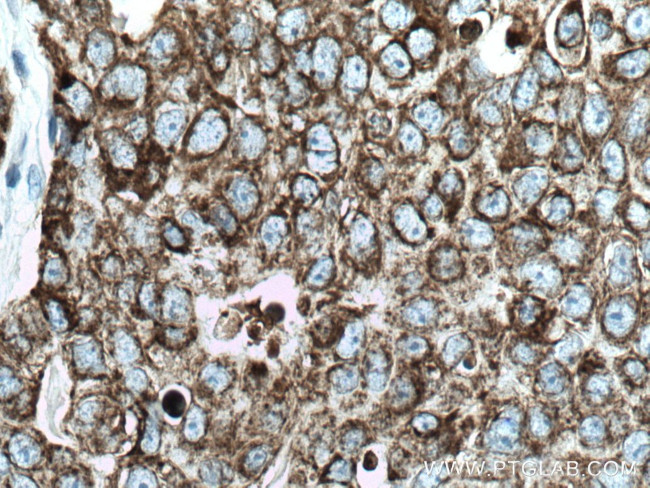
CKMT1A Antibody in Immunohistochemistry (Paraffin) (IHC (P))
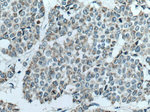
CKMT1A Antibody in Immunohistochemistry (Paraffin) (IHC (P))

Search
Proteintech
CKMT1A Polyclonal Antibody
{{$productOrderCtrl.translations['antibody.pdp.commerceCard.promotion.promotions']}}
{{$productOrderCtrl.translations['antibody.pdp.commerceCard.promotion.viewpromo']}}
{{$productOrderCtrl.translations['antibody.pdp.commerceCard.promotion.promocode']}}: {{promo.promoCode}} {{promo.promoTitle}} {{promo.promoDescription}}. {{$productOrderCtrl.translations['antibody.pdp.commerceCard.promotion.learnmore']}}
产品信息
15346-1-AP
种属反应
已发表种属
宿主/亚型
分类
类型
抗原
偶联物
形式
浓度
规格
纯化类型
保存液
内含物
保存条件
运输条件
产品详细信息
Immunogen sequence: SERRRLYPP SAEYPDLRKH NNCMASHLTP AVYARLCDKT TPTGWTLDQC IQTGVDNPGH PFIKTVGMVA GDEETYEVFA DLFDPVIQER HNGYDPRTMK HTTDLDASKI RSGYFDERYV LSSRVRTGRS IRGLSLPPAC TRAERREVER VVVDALSGLK GDLAGRYYRL SEMTEAEQQQ LIDDHFLFDK PVSPLLTAAG MARDWPDARG IWHNNEKSFL IWVNEEDHTR VISMEKGGNM KRVFERFCRG LKEVERLIQE RGWEFMWNER LGYILTCPSN LGTGLRAGVH IKLPLLSKDS RFPKILENLR LQKRGTGGVD TAATGGVFDI SNLDRLGKSE VELVQLVIDG VNYLIDCERR LERGQDIRIP TPVIHTKH (41-417 aa encoded by BC001926 )
靶标信息
Mitochondrial creatine kinase (MtCK) is responsible for the transfer of high energy phosphate from mitochondria to the cytosolic carrier, creatine. It belongs to the creatine kinase isoenzyme family. It exists as two isoenzymes, sarcomeric MtCK and ubiquitous MtCK, encoded by separate genes. Mitochondrial creatine kinase occurs in two different oligomeric forms: dimers and octamers, in contrast to the exclusively dimeric cytosolic creatine kinase isoenzymes. Many malignant cancers with poor prognosis have shown overexpression of ubiquitous mitochondrial creatine kinase, this may be related to high energy turnover and failure to eliminate cancer cells via apoptosis. Ubiquitous mitochondrial creatine kinase has 80% homology with the coding exons of sarcomeric mitochondrial creatine kinase.
仅用于科研。不用于诊断过程。未经明确授权不得转售。
生物信息学
蛋白别名: Acidic-type mitochondrial creatine kinase; Creatine kinase U-type, mitochondrial; creatine kinase, mitochondrial 1 (ubiquitous); creatine kinase, mitochondrial 1, ubiquitous; Mia-CK; U-MtCK; Ubiquitous mitochondrial creatine kinase; unnamed protein product
基因别名: CKMT; CKMT1; CKMT1A; CKMT1B; mi-CK; mia-CK; Mt-CK; ScCKmit; U-MtCK; UbCKmit
UniProt ID: (Human) P12532, (Mouse) P30275
Entrez Gene ID: (Human) 548596, (Mouse) 12716, (Rat) 29593